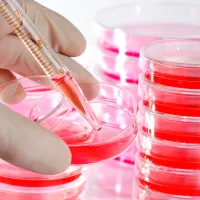
SABOURAUD DEXTROSE AGAR

Bioreux Products
- All Products
-
- Sequencing and Bioinfomatics
- Nucleic Acid Extraction/Purifications
- Nucleic Acid Electrophoresis
- Recombinant Clone Expression
- Plasmids
- Molecular Biology Auxiliary Reagents
- Reagents and Buffer
- PCR and RT-PCR Kits
- Lateral Flow and Nanotechnology
- Molecular Cloning and Cloning Reagents
- Proteomics
- Hematology and Latex Kits